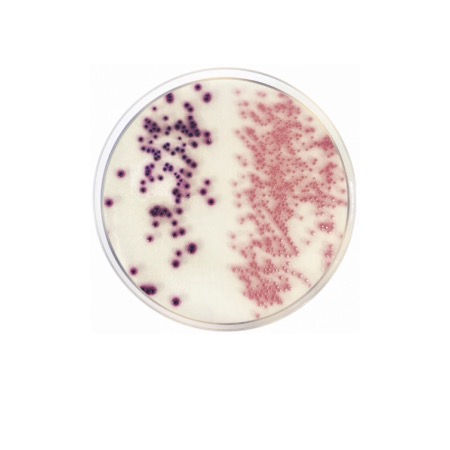
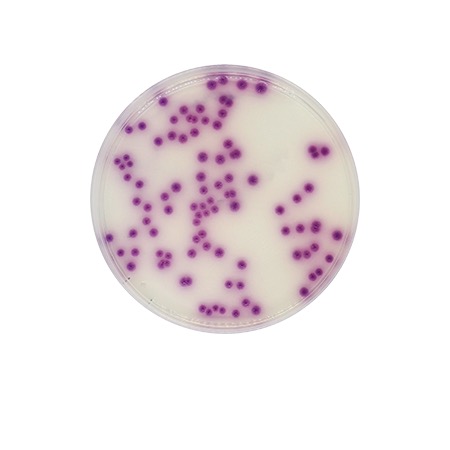
product

Chromogenic Coliforms Agar (CCA) ISO is a dehydrated selective medium designed for the detection and enumeration of coliform bacteria and E. coli in water by membrane filtration. The medium contains chromogenic substrates that enable direct differentiation of E. coli and other coliforms based on colony color. It is widely used in drinking water, environmental and process water quality control in accordance with ISO standards.
Chromogenic Coliforms Agar (CCA) ISO, catalogue No. 2080, is a dehydrated selective and differential culture medium intended for the simultaneous detection and enumeration of coliform bacteria and Escherichia coli in water samples. The medium is based on chromogenic substrates that are cleaved by specific bacterial enzymes, allowing direct visual differentiation of target organisms.
After membrane filtration and incubation, E. coli forms characteristic dark blue to violet colonies due to β-glucuronidase activity, while other coliform bacteria produce pink to red colonies as a result of β-galactosidase activity. Non-target microorganisms are largely inhibited by the selective components of the medium. The method allows rapid and reliable assessment of microbiological water quality.
Advantages
- Simultaneous detection and enumeration of total coliforms and E. coli on a single medium.
- Clear chromogenic differentiation based on enzyme activity.
- Suitable for membrane filtration technique.
- Complies with ISO methods for microbiological water analysis.
- Widely used for drinking water, environmental and industrial water control.
Technical specifications
| Pack size | 500 g |
| Intended use | Detection and enumeration of coliforms and E. coli in water |
| Method | Membrane filtration |
| Typical incubation | 36 ± 2 °C, 21–24 h |
| Typical colony appearance | E. coli: dark blue/violet; other coliforms: pink/red |
| Application field | Drinking water, environmental water, industrial water quality control |
| Chemical type | Microbial Culture Media |
| Brand | Condalab |
| Pack size | 500 g |